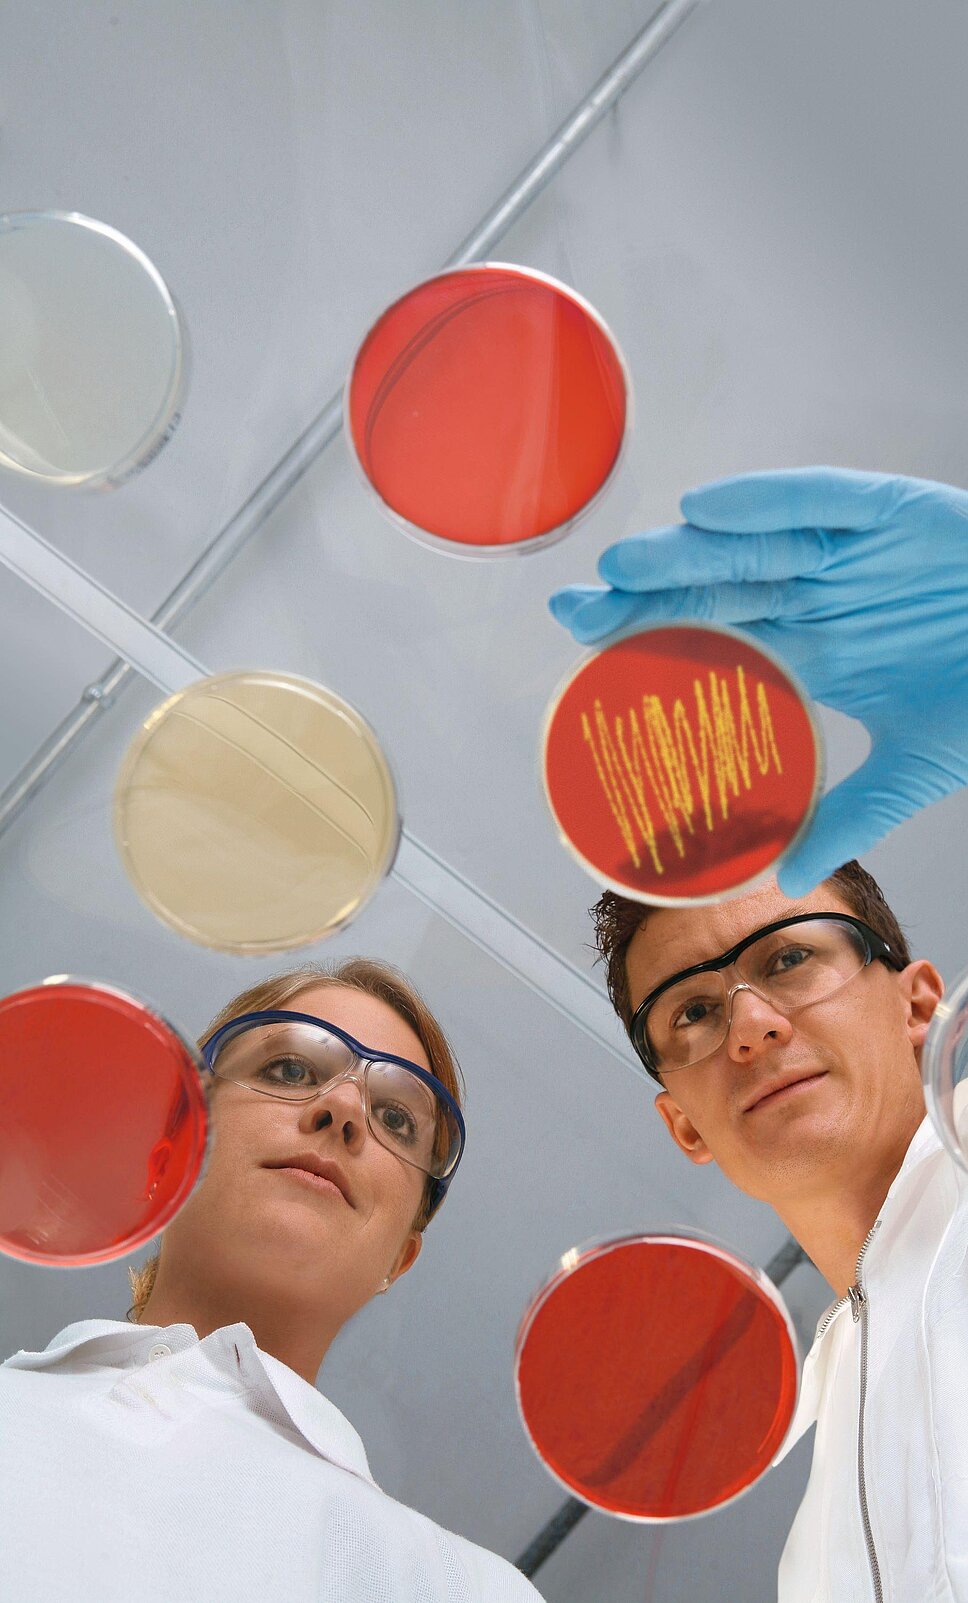

Pharmaindustrie. Unternehmen aus den USA und China drängen mit ihren Produkten in den Markt. Innovationen und Forschung können den Pharmastandort sichern – wenn die Rahmenbedingungen passen.
Innovation braucht einen Rahmen

Österreich ist ein attraktiver Standort für die Pharmaindustrie. Doch die Branche gerät zunehmend unter Druck. Es besteht die Gefahr, im globalen Wettbewerb abgehängt zu werden. Es braucht dringend Maßnahmen, damit europäische Pharmaunternehmen ihre Position für die Zukunft sichern können, denn China ist auf der Überholspur und die USA verteidigen ihre Führungsposition.
Europa wird als Standort für immer mehr Industrien unattraktiver. Unternehmen verlagern Teile ihrer Produktion in Länder, in denen kostengünstiger und mit weniger Regularien produziert werden kann. Sind diese Tendenzen in der Pharmaindustrie auch bereits spürbar? „Wir sehen dieses Thema der Abwanderung durchaus kritisch. Die europäische pharmazeutische Industrie ist eine relevante Industrie“, sagt Alexander Herzog, Generalsekretär der Pharmig, dem Verband der pharmazeutischen Industrie Österreichs mit rund 120 Mitgliedsunternehmen.
Der globale Wettbewerb verschärft sich, mit verstärkten Investitionen in das Gesundheitswesen muss Europa dringend zu den Vereinigten Staaten und China aufschließen, wenn es seine Position als Spitzenreiter bei Innovationen zurückgewinnen und damit die Pharmaindustrie langfristig halten will. Die gegenwärtige Situation analysiert Alexander Herzog aber wie folgt: „Europa diskutiert, Amerika probiert und China praktiziert. Während die USA und China ständig voranschreiten, verliert Europa an Terrain und tritt auf der Stelle.“ Damit ist man auch schon beim Kern des Problems angelangt.
Schlüsselindustrie
Europa kann es sich nicht leisten, diese hochinnovative Schlüsselindustrie zu verlieren. Nicht zuletzt der Ausbruch der Corona-Pandemie machte deutlich, wie wichtig die Pharmaindustrie für Europa ist, und dass Europa wirksame Forschungs- und Innovationsprogramme braucht.
Die europäische pharmazeutische Industrie trägt mit über 200 Milliarden Euro zur Bruttowertschöpfung (BWS) bei und sichert 2,5 Millionen Arbeitsplätze. Sie investiert jährlich 43 Milliarden Euro in europäische Forschung und Entwicklung (F&E) und liefert mit 135 Milliarden Euro die stärkste Handelsbilanz aller Industriesektoren der Europäischen Union. „Dieses Potenzial sollte zumindest erhalten bleiben. Aber die Tendenz scheint eine andere zu sein, denn die derzeitige Überarbeitung der Arzneimittelgesetzgebung sieht noch strengere Regulierungen vor, mehr Bürokratie und gleichzeitig eine Aufweichung des Schutzes des geistigen Eigentums“, so Pavol Dobrocky, Geschäftsführer von Boehringer Ingelheim. Denn wer forscht, möchte seine Erfindungen zumindest eine gewisse Zeit lang vor Nachahmung schützen. Fällt dieser Antrieb weg oder wird unattraktiv, wird sich die Forschungswelt woanders hin orientieren.

In die Flucht reguliert
„Ich will nicht zu pessimistisch klingen. Europa ist technologisch stark und wir sind innovationsstark. Aber der Vorsprung schmilzt, weil wir zunehmend in Regularien hineingepresst werden, die es der forschenden pharmazeutischen Industrie teilweise wirklich schwer machen, noch weiter in Europa zu bleiben“, bekräftigt auch Alexander Herzog. In der „pharmaceutical strategy“ der Europäischen Kommission sieht er eine extreme Verschlechterung für die Unternehmen der Pharmaindustrie. Um die Zukunft der Branche zu sichern, sollte Europa eine Vorwärtsstrategie vertreten und die besten Köpfe der Welt hier in Europa forschen und entwickeln lassen, doch dieser technologische Vorsprung würde so leichtfertig aufs Spiel gesetzt, wie er betont. Patentschutzfristen zu verkürzen, um die Produkte möglichst billig zu machen, schaffe ein Problem. „Der Vorschlag der EU ist in der pharmazeutischen Industrie extrem schlecht angekommen und hat die Abwanderungsgespräche und Abwanderungstendenzen, die ich vor allem in den Headquarters vernehme, noch verstärkt“, erklärt Herzog.
Generika als Zukunft?
Ein Markt würde sich mit der Erzeugung von Generika erschließen. Doch in den letzten Jahrzehnten hat China einen bedeutenden globalen Marktanteil in diesem Bereich aufgebaut. Ein Bereich, den die europäischen Unternehmen nur schwer abdecken können. Denn hier geht es vor allem um die Preise der Medikamente, erklärt Alexander Herzog. „In dem Moment, wo die Patente abgelaufen sind, ist sozusagen der Innovationsaufwand abbezahlt. Dann kommt es zu einem sehr starken Preisrückgang um teilweise 90 bis 95 Prozent gegenüber den Originatoren. Es dreht sich alles darum, wer dieses Produkt, das dann für die großflächige Allgemeinheit gut verfügbar ist, möglichst günstig herstellen kann.“ In Europa gibt es zwar noch Produktionsstätten, so werden seit fast 80 Jahren in Kundl in Tirol Antibiotika hergestellt, doch die heimischen Unternehmen werden es nicht schaffen, der billigste Produzent von Generika zu werden. „Hier geht es um einen globalen Wettkampf der Produktionskosten, noch zusätzlich Produktionen ins Land zu holen, um wieder Kinderhustensäfte oder Antibiotika hier zu produzieren, halte ich für fast ausgeschlossen. Ich glaube auch nicht, dass wir uns auf das konzentrieren sollten. Da geht es rein um Produktion, um Logistik und Produktionskosten. Das können andere billiger“, bringt es Herzog auf den Punkt.
Forschung und Entwicklung stärken
Für die Experten liegt die Zukunft der europäischen Pharmaindustrie eindeutig in der Forschung und Entwicklung. Hier nicht ins Hintertreffen zu geraten, sondern den Sektor auszubauen, ist das Ziel. Und es ist höchste Zeit, denn die Zahlen zeigen, wie stark Europa in den letzten Jahren an Innovationskraft verloren hat. Vor 25 Jahren kamen rund 50 Prozent aller neuen Therapien aus Europa, heute sind es nur noch etwa 20 Prozent. Die EU-Arzneimittelexporte sind zwischen 2021 und 2022 um 16 Prozent gestiegen, während die chinesischen Exporte um 121 Prozent stiegen. China verdoppelte seinen Marktanteil an den weltweiten Arzneimittelexporten von drei Prozent auf sechs Prozent. Die Hauptursache dafür ist der Mangel an Finanzmitteln für Innovationen. Zwischen 1990 und 2019 haben sich die Investitionen in Forschung und Entwicklung in Europa um das 4,9-Fache erhöht, in den Vereinigten Staaten jedoch um das 9,5-Fache, so die Daten der European Federation of Pharmaceutical Industries and Associations (EFPIA). Die Forschungs- und Entwicklungsinvestitionen in den USA haben demzufolge die europäischen im Jahr 2022 um 25 Milliarden Euro übertroffen. Anfang der 2000er Jahre waren es lediglich zwei Milliarden. Der Blick nach China zeigt, dass die Ausgaben für F&E in China jährlich um 12,9 Prozent zunehmen.
Und gerade die Finanzierung von Forschung ist der Knackpunkt, denn die Investitionen für die Entwicklung eines neuen innovativen Medikamentes sind hoch. Untersuchungen zufolge liegen die durchschnittlichen Kosten bei bis zu 2,6 Milliarden Dollar. In diesen Kosten sind die direkten Kosten für die Entwicklung des Arzneimittels enthalten sowie die damit verbundenen Fehlschläge, aber auch die Opportunitätskosten; das heißt, die indirekten Finanzierungskosten für derart lange und kostenintensive Entwicklungsprojekte.
Blick nach Österreich
Wie sieht es nun konkret in Österreich aus? Wie innovativ und forschungsstark ist Österreich? Bei der vergleichenden Bewertung von Forschungs- und Innovationsleistungen der EU-Mitgliedstaaten für das Jahr 2023 belegt Österreich Rang 6. Das „European Innovation Scoreboard“, das jährlich von der Europäischen Union veröffentlicht wird, stuft Österreich wieder als „Strong Innovator“ ein. Im Vergleich zu 2016 bedeutet das eine deutliche Verbesserung im Ausmaß von +6,4 Prozent. Damit liegt Österreich mit seiner Innovationsleistung über dem EU-Durchschnitt. Die Forschungsquote lag 2022 bei 3,18 Prozent und damit über dem europäischen Zielwert von drei Prozent. Speziell die pharmazeutische Industrie trägt durch Forschungsaufträge zur Wertschöpfung in Österreich bei: 2021 investierten Österreichs Unternehmen der pharmazeutischen Industrie 304 Millionen Euro in Forschung und Entwicklung.
Als gutes Beispiel dient das Regionalcenter Vienna (RCV) von Boehringer Ingelheim. Es ist das unternehmenseigene globale Zentrum für Krebsforschung. Rund 400 Mitarbeitende arbeiten derzeit in der Forschung – vor allem in der Onkologie, aber auch in den Bereichen Immunmodulation und NBE (New Biological Entities). Rund ein Viertel seines Umsatzes investiert das Unternehmen in die Forschung und Entwicklung. Am Wiener Standort wird um rund 60 Millionen Euro ein neues Krebsforschungsgebäude errichtet, die Eröffnung ist für September 2024 geplant.

Maßnahmen gefordert
Es muss auch die Anstrengung der Länder und der EU sein, die Unternehmen nicht nur in Europa zu halten, sondern auch neue Unternehmen nach Europa zu holen. „Und dafür stehen die Chancen gar nicht so schlecht“, wie Herzog betont. „Europa hat sehr viel zu bieten. Beginnend mit einer ausgezeichneten Lebensqualität über stabile politische Systeme, haben wir sehr viel, um Forscher und Unternehmen anzuziehen. Wenn die Rahmenbedingungen stimmen und ein politisches Commitment kommt, dann wären wir schon über den Berg.“ Die Strategische Agenda 2024-2029, die im Juni von Staats- und Regierungschefs verabschiedet wurde, beinhaltet als oberste Priorität das Engagement zur Verbesserung der Wettbewerbsfähigkeit der EU mit Schwerpunkt auf dem Aufbau von Kapazitäten in sensiblen Sektoren und Schlüsseltechnologien, einschließlich des Life-Science-Sektors. Dies ist ein positiver erster Schritt, der jedoch interdisziplinär umgesetzt werden muss. „Die Politischen Leitlinien von Ursula von der Leyen für die Amtszeit 2024–2029 fokussieren auf die Förderung von Forschung, Innovation, Wissenschaft und Technologie. Der Vorschlag zur Schaffung einer eigenen Life-Science-Strategie enthält wichtige Impulse für den Sektor. Diese Impulse erfordern konkrete Maßnahmen, um Europas Zukunft als Innovationsstandort zu stärken“, bekräftigt Dobrocky.
Europa braucht nun eine umfassende Strategie, um wettbewerbsfähig zu bleiben. Maßnahmen zur Förderung von Ideen zu Innovationen und von Innovationen zu Produkten sind notwendig. Der Aufbau eines Ökosystems, damit Europa der Standort für die Entwicklung und Herstellung neuer Technologien wird, ist erforderlich. Es fehlt ein eindeutiges Commitment zu Investitionen im Gesundheitswesen. Politische Maßnahmen zur Sicherung der Zukunft Europas als globaler Biopharma-Akteur fehlen ebenso. „Außerdem sollte eine kontinuierliche Bewertung der Auswirkungen neuer und bestehender Legislativvorschläge auf die Wettbewerbsfähigkeit des Sektors sowie bei Bedarf eine Umsetzung von Korrekturmaßnahmen stattfinden“, bekräftigt Dobrocky.

